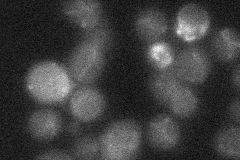
YPR155C

View description
Protein involved in regulation of mitochondrial expression of subunits 6 (Atp6p) and 8 (Atp8p) of the Fo-F1 ATP synthase; functions with Nca3p
Localization:
Intensity:
Fold change:
Significance:
-
C’ GFP library in SD

mitochondria25.57 -
N' NOP1pr-GFP in SD

mitochondria37.0558 -
N' TEF2pr-mCherry in SD

missing0 -
N' NATIVEpr-GFP in SD
mitochondria20.2946 -
N' TEF2pr-VC and Cyto-VN in SD

#N/A0 -
C’ GFP library in SD+DTT

mitochondria27.741.08No -
C’ GFP library in SD+H2O2

mitochondria28.471.11No -
C’ GFP library in Starvation Media

mitochondria28.611.11No -
C’ GFP library on the background of Pup2-DaMP

N/A -
C’ GFP library on the background of CCT mutant

N/A0N/AYes
